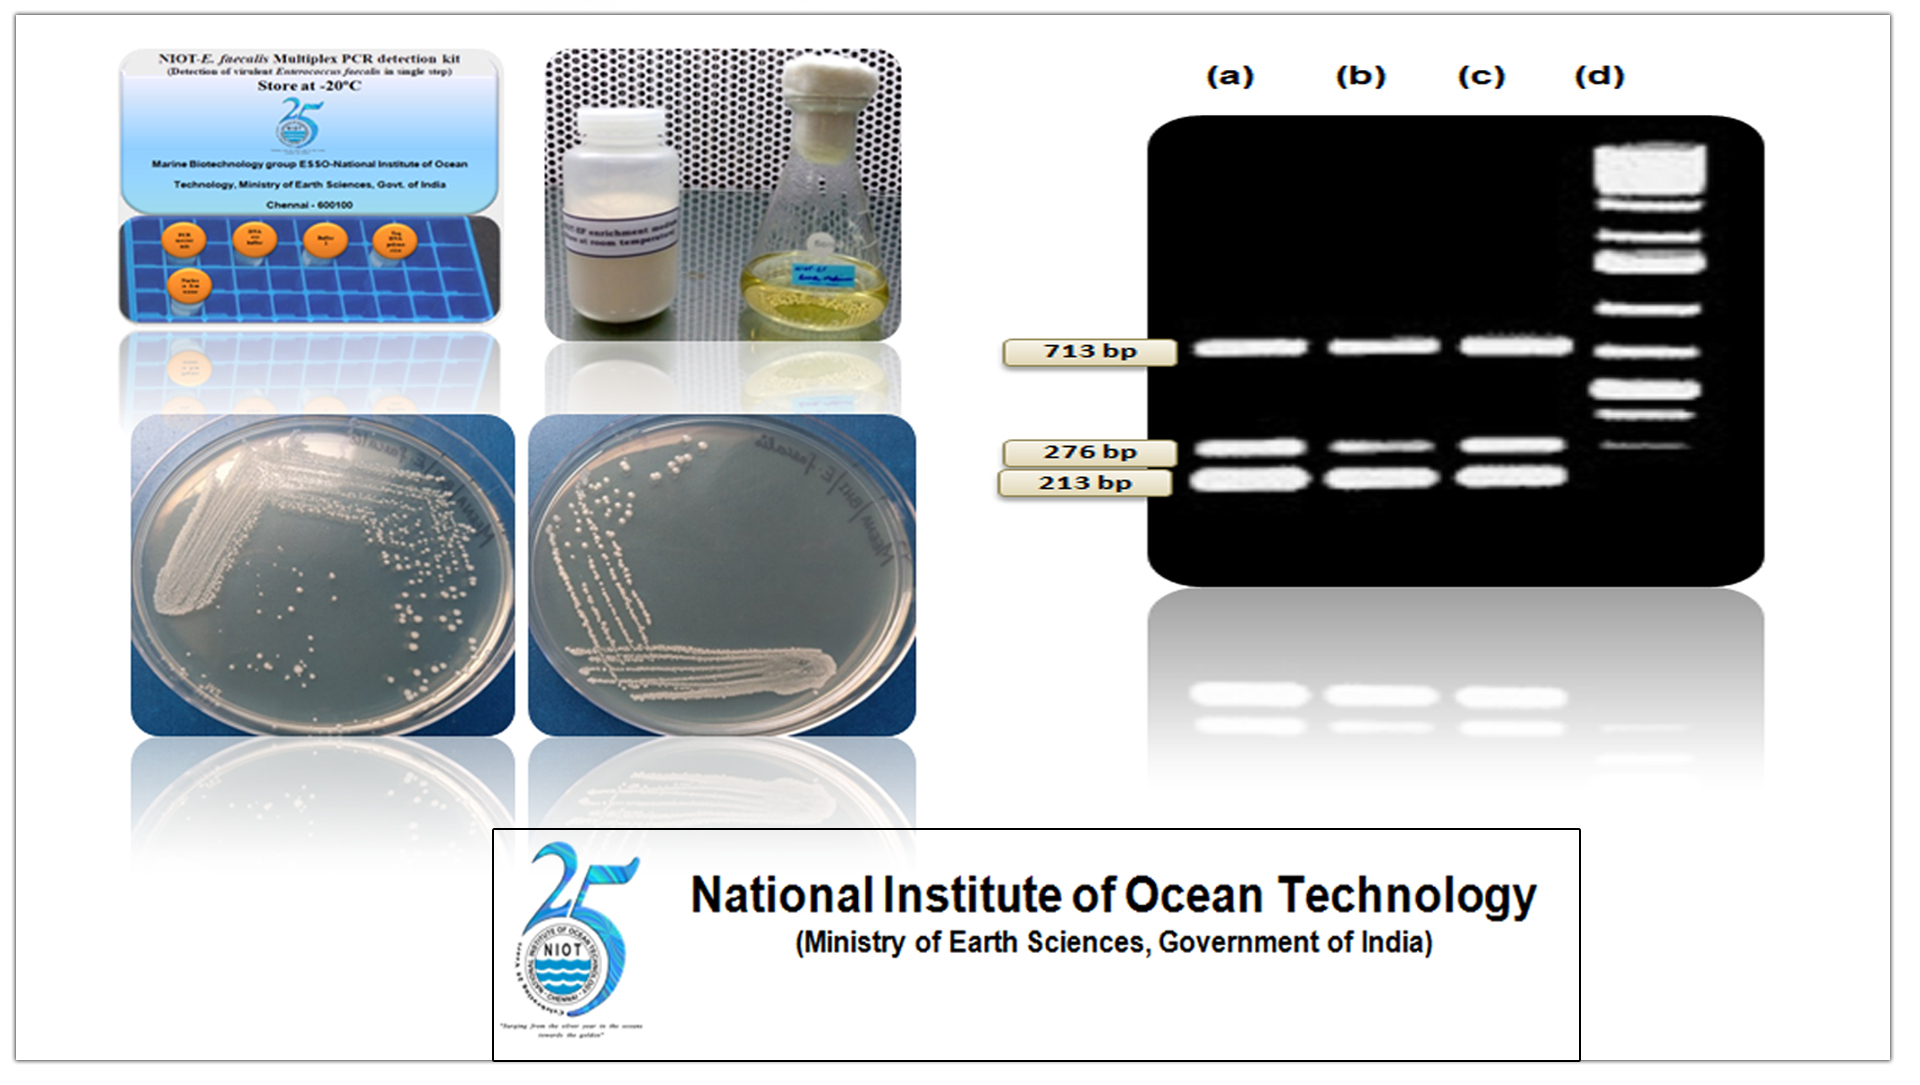

SAAI Sure
SAAI Sure E.faecalis Multiplex PCR Kit for Rapid detection of Pathogenic Enterococcus faecalis and its virulent genes in single step from Water Food &, Other samples
Description
NIOT - E. faecalis kit is an all-inclusive, ready to use kit which simplifies and expedite the process of detection of virulent genes in pathogenic E. faecalis (gelE-213 bp, asa1-713 bp, hyl-276 bp) within 6 hours in a single step.
NIOT - E. faecalis Multiplex PCR detection kit contains: NIOT - E. faecalis enrichment medium to attain sufficient cell growth within 3 hours,
Digestion buffer enable to extract the crude DNA from the pure and enriched cultures,
NIOT - E. faecalis Multiplex PCR master mix for the specified amplification and detection of virulent genes, Positive and negative PCR control mix helps to identify and interpret the virulence range of the pathogen.


